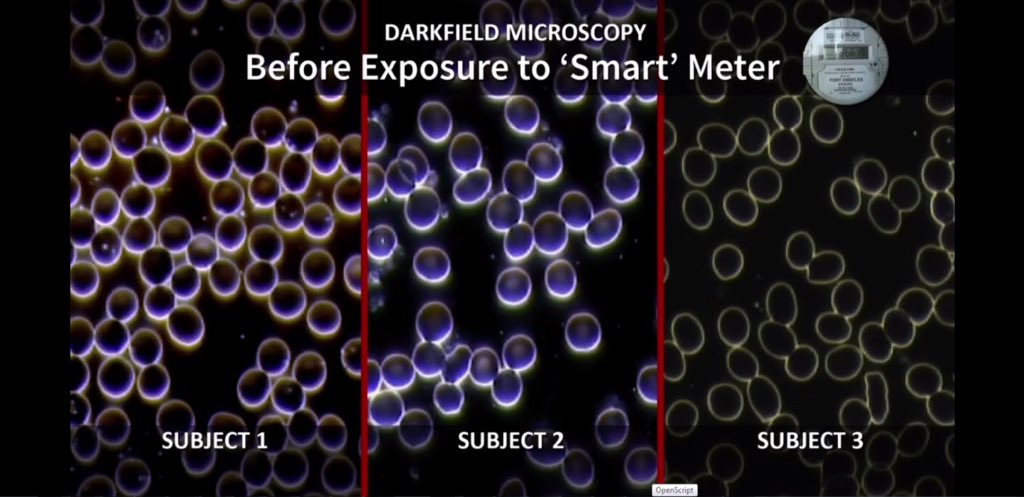

Por eso en Mexico, Rusia, Suiza, Suecia, Brasil la incidencia es muy diferente: muchos enfermos pocos muertos, como si el virus no pasara fronteras.
En estos lugares las muertes son por influenza, dengue, gripe y demás enfermedades que año con año matan incluso a más personas.
En estos lugares las muertes son por influenza, dengue, gripe y demás enfermedades que año con año matan incluso a más personas.
¿Muertos hay? Sí, como todos los años. Incluso menos porque ahora estamos encerrados y habra menos influenza.
Por eso la OMS advirtió una posible reinfección y ahora que empieza la temporada fuerte de influenza, todos serán coronavirus.
Por eso la OMS advirtió una posible reinfección y ahora que empieza la temporada fuerte de influenza, todos serán coronavirus.
Si se dan cuenta estamos todos encerrados porque la OMS dijo que NOOO iban a alcanzar los ventiladores y resulta que nunca fueron necesarios. 

¿Estás palomas también son conspiranoicas?
Es evidente, quien no se da cuenta es porque no quiere.
Es evidente, quien no se da cuenta es porque no quiere.
Casa ves hay gente con hipersensibilidad electromagnética.
Pero eso nunca lo verás en Discovery Channel o algún noticiero.
Pero eso nunca lo verás en Discovery Channel o algún noticiero.
Jeromy Johnson explica cómo pasó de no creer en el daño de las redes inalámbricas a tener que aislarse porque la hipersensibilidad le trajo muchos problemas de salud.
Busquen sus videos y consejos para disminuir la exposición WIFI a nuestros hijos.
Busquen sus videos y consejos para disminuir la exposición WIFI a nuestros hijos.
Tengo que hacer énfasis en que los países de primer mundo manejan WIFI públicas muy rápidas pero muy dañinas, el año pasado en Disney con miles de personas conectadas al WIFI de los parques mi celular navegaba con casi 300 megas y en mi casa junto al módem no pasa de 8O megas. 

Suiza sí está llevando protocolos de seguridad. Suiza es cede de la ONU, la OMS y el banco más importante de todos, el Bank of International Settlemens, BIS, o Banco de Pagos Internacionales.
Pinches casualidades ¿No?
Tampoco hubo cuarentena, les digo que es un virus raro.
Pinches casualidades ¿No?
Tampoco hubo cuarentena, les digo que es un virus raro.
Ellos quieren dominar...
Y si les digo que con estas antenas de radiofrecuencia 5G pueden monitorear metabólicamente a alguien e incluso analizar, interferir y modificar nuestras ondas cerebrales a control remoto.
¿Qué pensarían?
Es imposible.
¿Qué pensarían?
Es imposible.
Pensaba igual hasta hace poco que leí un libro de cómo se comunicaban durante la 2da Guerra Mundial y me llamó la atención que los militares de EUA que estuvieron cerca de los radares manifestaron problemas como dolor de cabeza, fatiga, cansancio y cambios repentinos de humor. 



Se investigó el tema hasta que lo patentaron.
Patente US3951134A
Apparatus and method for remotely monitoring and altering brain waves.
patentimages.storage.googleapis.com/80/46/32/d4239…
Patente US3951134A
Apparatus and method for remotely monitoring and altering brain waves.
patentimages.storage.googleapis.com/80/46/32/d4239…

Objetivos.
Un objetivo del invento es monitorear la actividad eléctrica del todo el cerebro o de un área específica en la misma medición.
Monitorear la actividad cerebral por control remoto.
Y afectar las ondas cerebrales transmitiendo señales electromagnéticas.
Un objetivo del invento es monitorear la actividad eléctrica del todo el cerebro o de un área específica en la misma medición.
Monitorear la actividad cerebral por control remoto.
Y afectar las ondas cerebrales transmitiendo señales electromagnéticas.

Esta patente de Rusia es un dispositivo para inmovilizar y/o dañar a un supuesto intruso.
RU2526478C2
Method and device of microwave electromagnetic impact at trespasser.
patentimages.storage.googleapis.com/94/76/b9/d6099…
RU2526478C2
Method and device of microwave electromagnetic impact at trespasser.
patentimages.storage.googleapis.com/94/76/b9/d6099…

Y es real.
Patente US6506148B2
Nervous system manipulation by electromagnetic fields from monitors
Por todos lados nos andan chingando.
patentimages.storage.googleapis.com/e2/4e/f9/3d4d5…


Patente US6506148B2
Nervous system manipulation by electromagnetic fields from monitors
Por todos lados nos andan chingando.
patentimages.storage.googleapis.com/e2/4e/f9/3d4d5…



Están de acuerdo que si la televisión puede manipular mi sistema nervioso través del campo electromagnético, es evidente que las pinches antenas de telefonía pueden hacer eso y más.
Así que por favor si alguien les dice que no es cierto, no insistan, esto es poco a poco.
Así que por favor si alguien les dice que no es cierto, no insistan, esto es poco a poco.
Conclusión, la red 5G incrementó el poder del Campo Electromagnético de la tierra y esto nos va a afectar a todos, poco a poco algunos se acostumbraran otros desarrollaran hipersensibilidad y otros moriran.
Los campos electromagnéticos nos dañan por todos lados.
Los campos electromagnéticos nos dañan por todos lados.
En cuanto al Coronavirus, el virus si existe pero en esta nueva pandemia no fue necesario que infectara a nadie. Las células que transportan oxígeno se ven afectadas por los CEM provocando que se peguen entre sí, formando Rouleaux y coágulos.
En caso de que la exposición sea prolongada como en USA, España, Italia y China (en China hay camionetas y camiones públicos 5G) los glóbulos rojos no transportan oxígeno adecuadamente provocando hipoxia y en casos severos anoxia, por eso vemos que la gente se desploma caminando.
En Guayaquil también se desplomaba la gente como en China en simultáneo. Imposible que el virus llegara a Ecuador desde China en pocos días y todos callaran fulminados. (Eso no sale en la TV)
Wuhan y Guayaquil fueron las dos ciudades donde Huawei hizo pruebas de su Chip 5G.
Wuhan y Guayaquil fueron las dos ciudades donde Huawei hizo pruebas de su Chip 5G.
Otra evidencia, Rusia, Mexico y Portugal siendo frontera con países “infectados” tuvo una diferencia de casos ABISMAL, así no se comporta un virus.
Por eso decían: hay dos cepas una moral y una normal.
Ahora ya sabes que es mentira.
Por eso decían: hay dos cepas una moral y una normal.
Ahora ya sabes que es mentira.
Donde no hay 5G la gente se muere, como todos los años, de dengue, influenza, gripe y neumonía. El problema es que la prueba PCR para diagnóstico, da resultados falsos positivos.
Por eso aunque no haya síntomas la prueba puede salir positiva.
Por eso aunque no haya síntomas la prueba puede salir positiva.
Todos los que trabajamos en un hospital sabemos que la neumonía es lo que mata a casi todos los que están comprometidos inmunológicamente. Mi tesis fue de infecciones nosocomiales (hospitalarias) y la neumonía fue el primer lugar seguido de infecciones de heridas quirúrgicas.
Si no te preocupa tú economía, te aseguro que estás a salvo, no te preocupes.
Si te preocupa tú economía, sal a producir porque ese será el verdadero problema.
Si te preocupa tú economía, sal a producir porque ese será el verdadero problema.
En NY se siguieron los protocolos del CDC, que marca la OMS para el tratamiento del paciente. El protocolo es intubarlos y dejarlos sedados esperando que su buena suerte les ayude. Porque la FDA y la OMS no aceptan que la Cloroquina, Interferon B y el Dioxido de Cloro funcionan.
Los médicos siguen el protocolo de la OMS para COVID, protocolo para neumonía viral, si es neumonía obviamente funcionará. No funciona porque túh SDRA que hay deprivacion de oxígeno, no es lo mismo que no haya oxígeno a qué sí haya pero no se transporte correctamente.
Y eso funcionaría si las personas que toman decisiones en la OMS no fueran sociopatas.
Si los glóbulos rojos están dañados y no pueden transportar oxígeno de nada sirve el ventilador, una transfusión sanguínea mejora el panorama pero ya se imaginarán que eso no lo dice la OMS.
Si los glóbulos rojos están dañados y no pueden transportar oxígeno de nada sirve el ventilador, una transfusión sanguínea mejora el panorama pero ya se imaginarán que eso no lo dice la OMS.
¿Y qué creen?
Hicieron a las prisas 3 ensayos con Remdesivir para crear credibilidad y apartir del 1ro de mayo es el único medicamento autorizado para el Coronavirus.
El encargado de esto es el Dr. Faucci, el mismo que obligó a la FDA a aprobar AZT para el VIH, siendo tóxico.


Hicieron a las prisas 3 ensayos con Remdesivir para crear credibilidad y apartir del 1ro de mayo es el único medicamento autorizado para el Coronavirus.
El encargado de esto es el Dr. Faucci, el mismo que obligó a la FDA a aprobar AZT para el VIH, siendo tóxico.



Es una fichita Tony Faucci. Aparte de todo está relacionado con el laboratorio de Wuhan.
Imaginen, son médicos y se dieron cuenta que no funciona el protocolo pero la OMS los respalda, o se arriesgan a cambiar pero si no funciona nadie te respalda.
Ok, arriesgan toman nuevas decisiones y en la siguiente guardia un doctor que no piensa igual vuelve a cambiar todo.
Ok, arriesgan toman nuevas decisiones y en la siguiente guardia un doctor que no piensa igual vuelve a cambiar todo.
Realmente se puede hacer poco, y más si opinas algo “diferente”.
Antes de las vacunas les comparto este video de los exosomas que ya les había comentado.
Los virus son exosomas y no son contagiosos.
Antes de las vacunas les comparto este video de los exosomas que ya les había comentado.
Los virus son exosomas y no son contagiosos.
Les recuerdo que un exosoma en el microscopio es exactamente igual que cualquier “supuesto” virus, dentro y fuera de las células. 



Les dejo estudios científicos que comprueban cómo los Campos Electromagnéticos (CEM) o Electromagnetic Fields (EMF) de equipos WIFI nos afectan, pero específicamente como y porque afectan a las células que transportan oxígeno (glóbulos rojos).
¿Cómo pueden negarlo?
¿Cómo pueden negarlo?
A los Campos Electromagnéticos también se les conoce como Electrosmog o Contaminación Electromagnética.
No más 5G, concluyo con este documento de la NASA de 1981 para que se den una idea desde hace cuantos años se sabe que afecta los glóbulos rojos, protones, sistema nervioso y ADN. Hasta el sistema digestivo posee su propio campo electromagnético.
ntrs.nasa.gov/archive/nasa/c…



ntrs.nasa.gov/archive/nasa/c…




Hace 10 años nos la quisieron aplicar pero no pudieron.
¿Pero saben cuando si funcionó?
En 1918 después de la Primera Guerra Mundial cuando por primera vez se ocupó la radiofrecuencia a nivel mundial para transmitir lo que conocemos como radio AM y FM.
Se hicieron pruebas desde 1917.
¿Qué pasó?
PANDEMIA DE LA GRIPE ESPAÑOLA.
En 1918 después de la Primera Guerra Mundial cuando por primera vez se ocupó la radiofrecuencia a nivel mundial para transmitir lo que conocemos como radio AM y FM.
Se hicieron pruebas desde 1917.
¿Qué pasó?
PANDEMIA DE LA GRIPE ESPAÑOLA.

Y después de la Segunda Guerra Mundial fueron los Radares.
¿Y qué pasó?
PANDEMIA.
Así desde 1918.
¿Y qué pasó?
PANDEMIA.
Así desde 1918.
En 1910 el informe Flexner, patrocinado por Rockefeller, cambia la medicina y mete los fármacos químicos.
1913 se privatiza la reserva federal y luego le quitan el oro a todos en Estadounidenes.
1914-1918 Primera Guerra Mundial
1918 Gripe española.
1913 se privatiza la reserva federal y luego le quitan el oro a todos en Estadounidenes.
1914-1918 Primera Guerra Mundial
1918 Gripe española.

Copien esto: “Red blood cells and Electromagnetic Fields” y búsquenlo en Google.
Absolutamente todo lo tecnológico tiene un campo electromagnético y afecta nuestras células.



Absolutamente todo lo tecnológico tiene un campo electromagnético y afecta nuestras células.




Les dejo el audio libro de “El Arcoíris Invisible” de Arthur Firstenberg.
Y no somos los únicos afectados, las aves también son afectadas.
Y no, la barrera de la especie impide que el coronavirus les afecte a las aves, antes de que se les ocurra pensar eso.
Italia, USA, Gales, España, Turquía.
Italia, USA, Gales, España, Turquía.
Incluso en China, los peces también se vieron afectados.
Estos hechos únicamente sucedieron en donde hay antenas 5G.
Estos hechos únicamente sucedieron en donde hay antenas 5G.
Y por último, lo que más me llamó la atención fue que en el crucero donde hubo 600 casos de coronavirus, varios de esos positivos compartieron camarote con personas que nunca se infectaron. ¿Cómo es posible eso con un virus que se extendió por todo el mundo en una semana? 



Medallion es la tecnología más potente sobre el mar y es posible gracias a la red 5G de los cruceros Princess. Veamos cómo nos explican su funcionamiento.
“El crucero tiene más capacidad satelital que muchas ciudades y más antenas que la mayoría de cruceros en el mundo”.
“El crucero tiene más capacidad satelital que muchas ciudades y más antenas que la mayoría de cruceros en el mundo”.
Y no solo eso, le dan un chip inteligente a cada pasajero de Medallion Class que sirve como llave y para ubicarlos por medio de 800 sensores por todo el barco. Desde la app pueden pedir lo que quieran y se lo llevan a donde esté.
Y los síntomas no se si se han dado cuenta que cada vez le agregan mas, ya al rato también la calvicie va a ser un síntoma. Me encanta que los médicos saben que son síntomas que nada que ver con virus respiratorios pero los aceptan porque son “atípicos”. 



Y casualmente son los síntomas que ocasiona la hipersensibilidad electromagnética, pongan atención en el segundo cuadro con 1.0.
Dolor de cabeza
Debilidad
Confusión
Agotamiento
Dificultad para respirar
Dolor de cabeza
Debilidad
Confusión
Agotamiento
Dificultad para respirar
Y para concluir con las vacunas. Les dejo estas gráficas del CDC donde es evidente que las enfermedades mencionadas fueron desapareciéndo únicamente con medidas de higiene y potabilizando el agua. Sin necesidad de vacunas.
Link. cdc.gov/healthywater/d…



Link. cdc.gov/healthywater/d…




Esto confirma que los virus son exosomas, que nunca entran a nosotros, son expulsados por nuestras células contaminadas. Con la potabilización del agua corriente se erradicaron la mayoría de los “virus”, las vacunas se aplicaron después.
Link. cdc.gov/nchs/data/vsus…



Link. cdc.gov/nchs/data/vsus…




Disminuyen los virus, llegan las vacunas y se disparan los casos de cancer. Recordemos que en 1917 se introducen las ondas de radio y comienzan a figurar la diabetes, partos prematuros, leucemias y cancer dentro de las principales causas de muerte. 



En este video de YouTube hablan muchas cosas de las vacunas que la mayoria creemos saber, me incluyo porque siempre me había vacunado. No tenemos que esperar a que nuestros hijos sufran alguna condición por las vacunas para saber y entender la realidad.
• • •
Missing some Tweet in this thread? You can try to
force a refresh